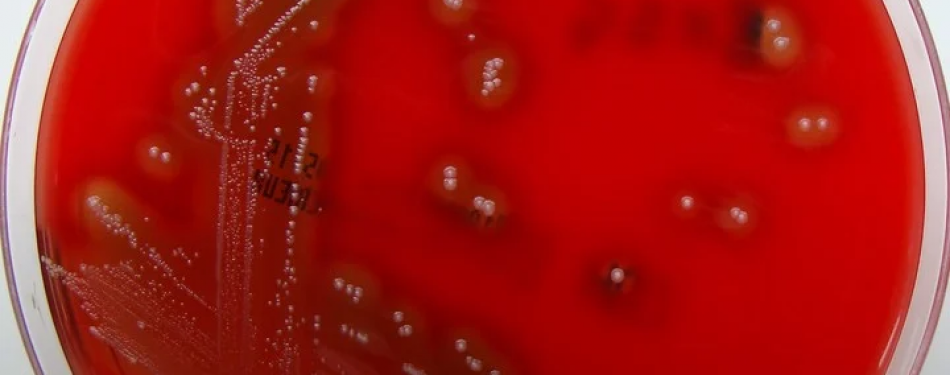

Información de Convenios, Novedades y Publicaciones Científicas

Departamento de Alumnos y Desarrollo Académico Jornadas del 25 de Agosto de 2023 -- La Fundación de Estudios Superiores Multidisciplinarios en Regulación y Ciencia, conjuntamente con...

Prensa FESMRC | Departamento de Asuntos Regulatorios y Gestión de Calidad | Prensa Opinión 14/08/2023 Autor: Juan Enrique D'Angelo | CEO en Formación Dirección: Departamento Científic...

Prensa FESMRC | MRC Group Argentina Dirección de Relaciones Públicas Con gran orgullo, en el día de la fecha, se ha llevado adelante la Firma de un Acuerdo de Cooperación y Colabor...
Departamento de Asuntos Regulatorios y Gestión de Calidad Cátedra de Salud Pública y Regulación Urbana El Streptococcus pyogenes es una bacteria con unos 80 serotipos diferentes que ...

Publicaciones Científicas - fesmrc.org.ar - mrcgroup.com.ar Julio 04 / 2023 - Argentina. Ciudad de Buenos Aires. Departamento de Docencia e Investigación Dirección Comercial y de Innov...

Prensa MRC GROUP | Prensa FESMRC | 04 de Julio de 2023 Fesmrc.org.ar | Dirección de Comunicaciones Entre 2019 y 2023 la pérdida de tiempo, inversiones y la falta de puestos laborales...

MRC Group informa que debido a problemas externos y las constantes fluctuaciones originadas desde la empresa ToWebs así como también de sus servidores que han ocasionado inconvenientes en ...

Publicaciones Científicas. MRC Group. Con el apoyo de la Fundación de Estudios (FESMRC) 04/06/2023 | Departamento Académico y de Investigación Científica Los últimos años han si...

Dirección de Investigación | Italia Continental MRC MRC Group & Fundación de Estudios Superiores Multidisciplinarios en Regulación y Ciencias. RESUMEN: La finalidad del presente a...